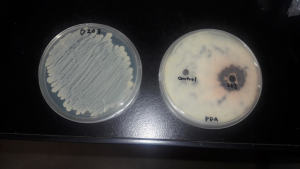

Hatake is a product that contains pure Bacillus amyloliquefaciens. The strain shows excellent plant pathogen fighting ability and high organic matter degradation activities.
Hatake microbe is derived from a cutting edge research made possible in laboratories equipped with DNA sequencers, gas chromatography-mass spectrometers (GC/MS), real-time PCR system, and other analytical equipment. Therefore our end products are consistently of the highest quality without any contamination of dust and other microorganisms.
With the best minds of microbiologists and agronomists, combined with our customer driven strategy, we present you with one of the most highly resilient and effective microbial inoculant catering for various types of crops.
Life begins at seed level. When Hatake is used as a seed treatment tool, this will assist farmers to achieve the maximum potential of the seed and traits right from the start. We cannot stress how important it is to nurture our seeds and build its immune system, growth potential and maximize yield.
Type | Frequency | Dosage | Application |
|---|---|---|---|
Seasonal Plant and Crops Vegetable (Chili, Tomato, Cabbage, Beans, etc) Ornamental Plants | 3 Days before planting Thereafter every 10-15 days | 100g (70L – 100L of water) is for 400m2 up to 800m2, or 1000 plants Use Chlorine Free Water | Spray on the leaves and stems until run off. Drench base of the plants so root system receives the full benefit of Hatake. |
Non Seasonal Plant and Crops | Intensive Less Intensive | 150g – 200g (50L of water) is for 400m2 up to 800m2, or 1000 plants Use Chlorine Free Water | Spray on the leaves and stems until run off. Drench base of the plants so root system receive the full benefits of Hatake. |
Strain H201 inhibits the hyphal tip growth in fungi
Light Microscope | Electron Microscope | Electron Microscope | |
|---|---|---|---|
Spore |
|
| |
Untreated |
|
|
|
Treated |
|
|
|